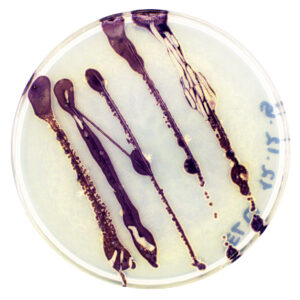
Foto2_Elusad_pigmendid

11. juunil, kell 16.30 esitavad Tallinna Ülikooli, sh Haapsalu Kolledži, ja Eesti Kunstiakadeemia tudengid õppetöö käigus teostatud projekti „ELUsad pigmendid”, mille raames uuriti bakteripigmendi kasutamise võimalikkust tekstiilide värvimisel. Ainulaadseks teeb tudengite saavutuse see, et sinakaslilla pigmendi eraldamine õnnestus ühe Eestis isoleeritud bakteri Rheinheimera baltica abil.
Tegemist on viimaste aastate ühe innovatiivseima suunaga alternatiivsete värvimismeetodite maailmas, mis proovib leida looduslikke ja jätkusuutlikke lahendusi tekstiilitööstusest tingitud saastatuse teemale.
Bakteripigmentidega värvimine võib anda võimaluse oluliselt vähendada tekstiilitööstuse peamisi probleeme ja mõjusid keskkonnale, vähendades vee kasutamist ja kemikaalide sattumist ökosüsteemi.
Kuigi koroona tõttu olid ülikooli laborid suletud ja osa tööst lükkub edasi, õnnestus siiski enne eriolukorda Eesti noortel teadlastel ja disaineritel panna üks Eestis isoleeritud bakter – Rheinheimera baltica – kasvama ja eraldama sinakaslillat pigmenti laboritingimustes. Samuti kasvatati seda tekstiilil selliselt, mis annab lootust, et tulevikus on võimalik arendada bakteri ja disaineri “koostöös” uuenduslikke mustreid ja visuaale, mis võib kaasa tuua ka paradigmamuutusi esteetikas.
Vaatamata sellele, et konkreetne õppeprojekt kevadsemetriga lõppeb, on Eesti Kunstiakadeemia tekstiilidisaini magistrandil Kristel Aimee Lauril soov antud teemaga edasi minna ja leida koostööpartnereid nii teadlaste kui ka ettevõtjate hulgast. „Olen alati olnud uudishimulik ja idealist. Antud suund on üheks võimaluseks uurida, kas selline lähenemine võib aidata midagi maailmas paremaks muuta. Mind on paelunud erinevate distsipliinide omavaheline koostöö ja selle potentsiaal. Kui seda täiendab veel looduse tarkus ja ilu, siis on tunne, et kõik on võimalik ja imesid juhtub. Just seda tunnet antud projekt pakkus ja võiks pakkuda ka edaspidi” ütleb Laur.
Projekti juhendasid Kairi Koort Tallinna Ülikoolist (TLÜ) ja Marie Vinter Eesti Kunstiakadeemiast
Meeskond: Piia Hurt (TLÜ), Piret Kartus TLÜ), Kristel Aimee Laur (Eesti Kunstiakadeemia), Andres Niroda (TLÜ) , Käthlin Paas (TLÜ Haapsalu Kolledž), Polina Tereshchenko (TLÜ)
*TLÜ ELU ehk erialasid lõimiv uuendus on projekt- ja probleemõppel põhinev erialasid lõimiv ehk interdistsiplinaarne õppeaine, mille raames üliõpilased koostöös õppejõudude ja ülikooli väliste partneritega teostavad erialadeülese probleemipüstitusega projekte.
Lisainfo: ELU esitluspäevaga saab liituda siin: http://tiny.cc/ELUesitlused
Kairi Koort, kairi.koort@tlu.ee
Marie Vinter, marie.vinter@artun.ee
Kristel Laur, kristel.laur@artun.ee, tel. 52 22422